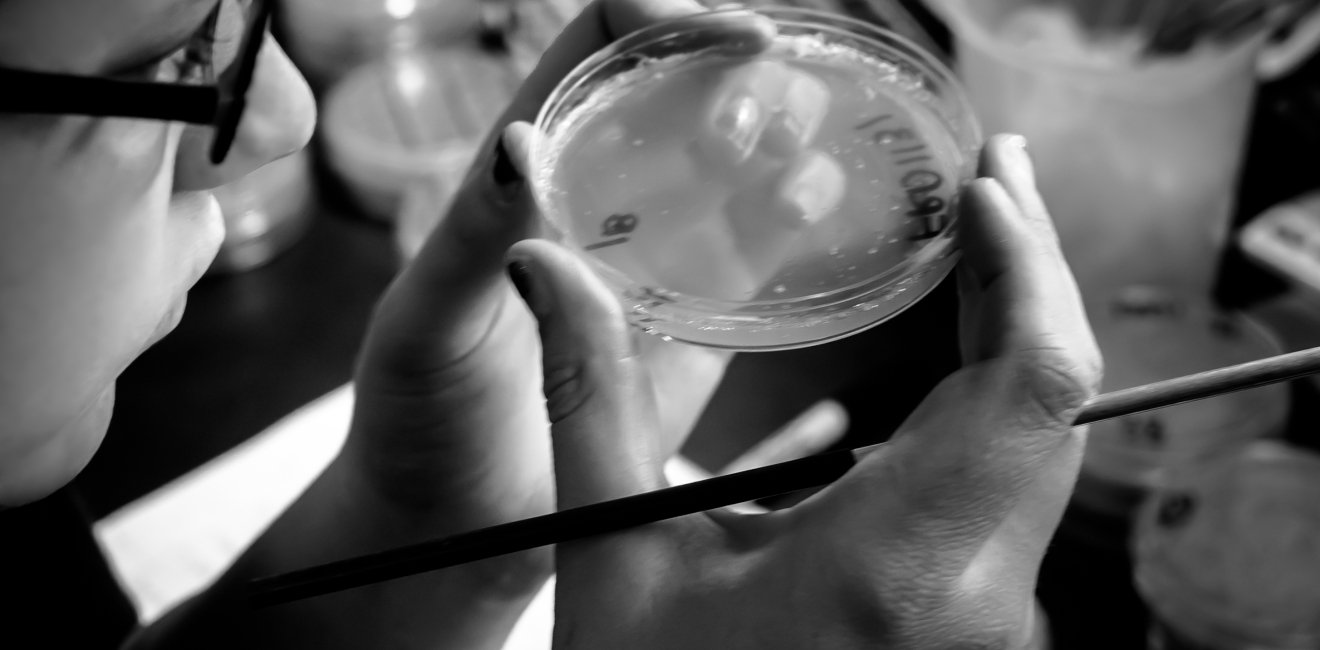
Person with petri dish

A blog of the Science and Technology Innovation Program
This blog post is part of a series on physical tools for science with THING Tank project. It follows the author’s participation in the Creative Commons Certificate for Librarians course to learn more about copyright and open licensing. Although this blog post touches on legal topics, it should not be considered legal advice.
This work is licensed under a Creative Commons Attribution 4.0 International License.
As open science expands its impact, many conversations focus on the important work of documentation and dissemination, building a culture of sharing within communities of scientists (professional and not)1, and asking all scientists to share all parts of their scientific process broadly and without reservation (Gymrek and Farjoun, 2016; Hampton et al., 2015). Equally important, however, is aligning this culture of openness and sharing with legal systems of intellectual property. These legal systems have limited sharing and prioritize “closed” ideas and content, and hold scientists back in unintended, and sometimes unknown, ways. Fortunately, champions of openness are generating legal tools that scientists can use – easily, and for free – to share their work both legally and openly, with only some (chosen) rights reserved.
One particularly important area of intellectual property – copyright law – protects your ownership of your scientific work, whether you realize it or not, and whether you want it to or not. Copyright describes the exclusive rights to control who uses, copies, distributes, performs, and adapts a creative work, by a creator or copyright owner2 (United States Copyright Office, 2019). Copyright applies to creative content; in other words, the expression of facts or ideas. In science, this can include images, graphics, and figures; presentations and blog posts; software, code and plans for other digital tools and methods; designs and documentation for physical tools, such as lab or field equipment; and articles and publications – in other words, many of the tools and methods of scientific progress! Copyright applies automatically as soon as the content is written, recorded, or otherwise shareable (United States Copyright Office, 2019). To allow work to be broadly distributed, adapted, and used in ways that comply with copyright law, scientists must actively designate an alternative to the default “all rights reserved” of the copyright system (Creative Commons, 2020). One such alternative is open licensing (e.g. Creative Commons licensing), that uses a “some rights reserved” approach to copyright.

Beyond Copyright
Beyond the the expression of ideas, facts or tools, to understand the role of intellectual property in scientific work, one must also consider elements that are facts (as these are not regulated by copyright), as well as elements that are useful objects, technical works, ideas or inventions (as these relate to patent law) (Dryden et al. 2017; Weinberg 2013; Creative Commons, 2020). For example, unless creative, data are often not copyrightable (Creative Commons FAQ); however, the expression of that data, such as the layout of a table, a graph, or a figure, and even the format of a dataset and database structure, is regulated by copyright.
Open Licensing
With a basic understanding of the types of intellectual property, open licenses can be used with minimal effort, and for free (Creative Commons, 2020). These licenses not only protect the creator and the users of a creative work, they also play an important signalling role, by communicating to those reading and using a creative work that the creator wants it shared, and wants it used as broadly as possible. Open licenses make creative work more broadly accessible and available, and allow others to build on it and multiply its impact – including by sharing helpful improvements and modifications back with the creator (McKiernan et al., 2016). These licenses allow the licensor to reserve specific rights related to commercial use, sharing of modifications, and requiring that the same or similar license is applied to derivative work (i.e. share-alike, or copyleft).
Licensing Your Creative Content with Creative Commons Licenses
Created in response to the tension between the copyright system and the sharing that the internet and new technology enables, Creative Commons licenses allow creators to share their content without violating copyright law, and on flexible terms. They are free, available for public use, and require attribution to creators or copyright owners. Creative Commons licenses are the most well-known and widely used open licenses; for example, Creative Commons licenses are integrated into many content platforms, such as Wikipedia, Flickr, and Youtube. Due to the ubiquity of Creative Commons licenses, these open licenses are broadly accepted as a standard in open licensing.
The Creative Commons website lists the six license options, and describes how to attribute. The license with the most flexible terms, CC BY, requires only that the work is attributed, and is the simplest and often most effective choice for an open license; note also that many open communities do not consider restrictions on commercial use (e.g. CC BY NC) to be fully “open” (Morin et al., 2012; Marszalek and Flintoft, 2016).
Often, Open Access publications include a Creative Commons license for all published works, making publishing open access an especially convenient option.

Licensing your Data, Software, and Hardware with Open Licenses
Creative Commons licenses are often used for open data, though data reuse is easiest when data are designated directly to the public domain (Creative Commons FAQ; Panton Principles), such as through the Creative Commons Public Domain Mark (CC0), which is not a license but a label identifying works in the public domain (Creative Commons, 2020).
Open licenses for code and software, although similar to Creative Commons licenses in approach, should be considered separately (Creative Commons FAQ). To license software or code openly, an Open Source Software (OSS) license includes options and considerations specific to software (Marszalek and Flintoft, 2016). Morin et al. (2012) lists many popular OSS licenses (e.g. MIT, Apache, or GPL) and their attributes. It also further describes the relative value of proprietary or open licenses, including important considerations and the terms that apply. Github’s Choose a License tool will help, too. Github’s Choose a License tool is itself licensed with a Creative Commons license, CC BY.
If a scientific work includes the design and use of hardware, physical tools, or sensors, open licensing is just as important, but the appropriate choice of a license is less clear-cut.
Tool designs, documentation, or code can be shared through a Creative Commons license, an OSS license, or an Open Hardware License, depending on the nature of the content. Importantly, sharing hardware openly requires attention to both the idea itself, which can be impacted by patent law, as well as documentation or design (files, code, or other documentation) that expresses the idea, which is covered by copyright law (Dryden et al., 2017). Moreover, the concept of an open license does not seamlessly translate to physical tools; open licenses like Creative Commons can apply to the digital manifestation of a tool (e.g. the documentation, design, or software), but not the physical tool itself. Open hardware communities are working to further clarify and provide options for open licensing and hardware; for example, an updated version of the CERN Open Hardware License was just released (CERN, 2020).
Challenges with Open Licensing and Open Science
Although open licenses may be applied without extensive legal knowledge, challenges quickly arise in unique or complex situations. Continuing to deepen an understanding of open practices in science and intellectual property will serve users and their communities well. To do so, resources such as the Creative Commons Certificate course are invaluable.
Finally, to fully embrace openness in science, we need both individual actions and systemic change (McKiernan et al., 2016; Hampton et al., 2015). Individual actions, such as using open licenses and doing the work of documenting and sharing scientific products, are enormously beneficial to garnering the benefits of open science at an individual level. Ideally, they further signal to institutions that open practices are important for science but ultimately, we should continue to advocate for open science at the institutional level. Potential avenues for policy shifts at the institutional level include investments in Open Access, Open Educational Resources, and re-prioritizing reward systems for scientists (SPARC Europe, 2020; Nosek et al., 2015). At the national and international level, policy change could include Open Science requirements for public funding (Dryden et al., 2017; Nosek et al., 2015) and international agreements for coordination on open science practices. It is only through institutional action that some of the barriers impeding individual advocates of open science can truly be addressed.
Endnotes
1. By scientist, this post intends to include anyone who participates in the process of science, whether in a professional context, as a citizen scientist or community scientist, or as someone communicating about science.
2. In many cases, work created within the scope of employment is owned by the employer, due to a doctrine known as “work-for-hire” (Creative Commons, 2020)
References
CERN, 2020. CERN Open Hardware License. Retrieved August 13, 2020 from https://cern-ohl.web.cern.ch/.
Creative Commons (2020, June). Creative Commons for Educators and Librarians [Certificate Course Content]. American Library Association. https://certificates.creativecommons.org/about/certificate-resources-cc-by
Dryden, M. D., Fobel, R., Fobel, C., & Wheeler, A. R. (2017). Upon the shoulders of giants: open-source hardware and software in analytical chemistry. Analytical chemistry, 89(8), 4330-4338. https://doi.org/10.1021/acs.analchem.7b00485
Gymrek, M., & Farjoun, Y. (2016). Recommendations for open data science. GigaScience, 5(1), s13742-016. https://doi.org/10.1186/s13742-016-0127-4
Hampton, S. E., Anderson, S. S., Bagby, S. C., Gries, C., Han, X., Hart, E. M., ... & Mudge, J. (2015). The Tao of open science for ecology. Ecosphere, 6(7), 1-13. https://doi.org/10.1890/ES14-00402.1
Marszalek, R. T., & Flintoft, L. (2016). Being open: our policy on source code. Genome Biology, 17(172). https://dx.doi.org/10.1186%2Fs13059-016-1040-y
McKiernan, E. C., Bourne, P. E., Brown, C. T., Buck, S., Kenall, A., Lin, J., ... & Spies, J. R. (2016). Point of view: How open science helps researchers succeed. elife, 5, e16800. https://doi.org/10.7554/eLife.16800
Author


Science and Technology Innovation Program
The Science and Technology Innovation Program (STIP) serves as the bridge between technologists, policymakers, industry, and global stakeholders. Read more